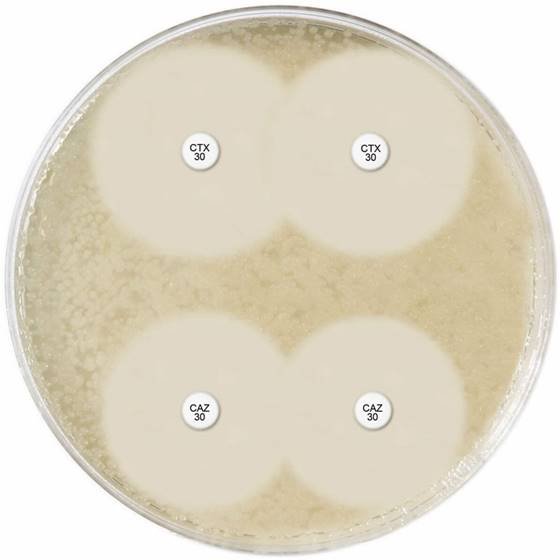

CEFOTAXIME ESBL ID DISC SET
150 Tests, Three paired sets of cartridges for the detection of Extended Spectrum Beta-Lactamases:
Cefotaxime 30µg discs (x 3)
Cefotaxime 30µg discs + Clavulanic acid 10µg discs (x3)
Three paired sets of cartridges for the detection of Extended Spectrum Beta-Lactamases:
Cefotaxime 30µg discs (x 3)
Cefotaxime 30µg discs + Clavulanic acid 10µg discs (x3)
Only logged in customers who have purchased this product may leave a review.

Reviews
There are no reviews yet.